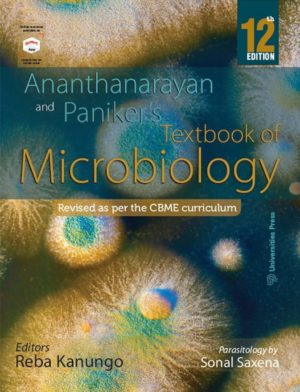
Textbook of Microbiology by Ananthnarayan & Panikers - 12th edition

Medical Books
Showing 1–16 of 28 resultsSorted by popularity
-

SINGHAL’S TOXICOLOGY AT A GLANCE – 9th edition
₹350.00 Read more -

Text Book of Materia Medica – 5th edition, by S. K. Dubey
₹495.00 Read more -
Save ₹145.00!

Inderbir Singh Textbook of Human Histology – 10th edition
Original price was: ₹995.00.₹850.00Current price is: ₹850.00. Add to cart -
Save ₹1,005.00!

B D Chaurasia’s Human Anatomy 9th edition, Volume 1, 2, 3 & 4 Set
Original price was: ₹2,870.00.₹1,865.00Current price is: ₹1,865.00. Add to cart -
Save ₹60.00!

Textbook of Microbiology by Ananthnarayan & Panikers – 12th edition
Original price was: ₹1,250.00.₹1,190.00Current price is: ₹1,190.00. Add to cart -
Save ₹239.00!

B D Chaurasias – Human Anatomy For Dental Students 4th edition
Original price was: ₹1,195.00.₹956.00Current price is: ₹956.00. Add to cart -
Save ₹105.00!

Textbook of Physiology by A K Jain – 10 edition
Original price was: ₹2,095.00.₹1,990.00Current price is: ₹1,990.00. Add to cart -
Save ₹180.00!

Biochemistry by Satyanarayana & Chakrapani – 6th edition
Original price was: ₹1,825.00.₹1,645.00Current price is: ₹1,645.00. Add to cart -
Save ₹420.00!

Textbook of Pathology by Harsh Mohan – 9th edition
Original price was: ₹2,795.00.₹2,375.00Current price is: ₹2,375.00. Add to cart -

Health Psychology by Shelley E. Taylor
₹700.00 Add to cart -
Save ₹315.00!

Essentials of Medical Physiology (Free Review of Medical Physiology) by Sembulingam – 9th edition
Original price was: ₹2,095.00.₹1,780.00Current price is: ₹1,780.00. Add to cart -

Textbook of Biochemistry for Medical Students
₹1,695.00 Read more -
Save ₹180.00!

BD Chaurasia’s Human Anatomy, Volume 3 – Head and Neck, Volume 4- Brain- Neuroanatomy
Original price was: ₹1,195.00.₹1,015.00Current price is: ₹1,015.00. Add to cart -
Save ₹155.00!

BD Chaurasia’s Human Anatomy Volume 2, Regional and Applied Dissection and Clinical, Lower Limb Abdomen and Pelvis – 10th edition
Original price was: ₹1,050.00.₹895.00Current price is: ₹895.00. Add to cart -

Practical Microbiology for MBBS by C P Baveja
₹1,595.00 Add to cart -

Biochemistry
₹1,675.00 Add to cart